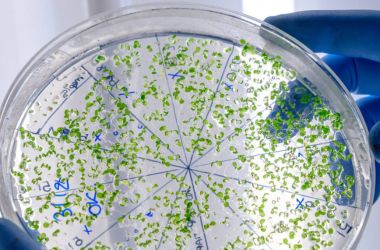

CPCB (MoEF) Approved | NABL Accredited | BIS Approved & ISO Certified
S&R ENVIRO LAB LLP
We offer Stack Emission monitoring from DG sets, boilers, and furnaces.
Our services include Ambient and Indoor Air Quality, Ambient/Work Zone Noise, and Lux Level testing.
Comprehensive Water Testing covers drinking, ground, surface, wastewater, and construction water.
We also specialize in Soil, Sludge, and Microbiological testing for complete environmental assessment.
We are the Industry Experts
A certified Quality Control Testing Laboratory
We offer a wide range of third-party quality control testing services to meet all your testing needs.
30+
Experienced Professional Staff
5000+
Samples tested annually
Experienced Team for
Quality Services Only
Stack Emission from DG Set, Boiler, Furnace
Measures pollutants released into the air, ensuring compliance with environmental norms.
Helps industries monitor combustion efficiency and reduce harmful emissions.
Ambient Air Quality
Analyzes outdoor air pollutants like PM, SO₂, NOx, and CO.
Ensures healthy air quality around industrial and residential areas.
Ambient Noise
Monitors environmental noise levels caused by traffic, industry, or other sources.
Helps assess compliance with CPCB and local noise standards.
Indoor Air Quality
Tests pollutants like CO₂, VOCs, dust, and allergens inside buildings.
Ensures a safe, healthy, and comfortable indoor environment.
Work Zone Noise
Measures noise levels in industrial and construction zones.
Protects workers’ health and ensures regulatory compliance.
Water Testing
Analyzes physical, chemical, and biological parameters in water.
Ensures water safety, usability, and regulatory compliance for multiple purposes.
Microbiological Testing
Detects harmful bacteria, viruses, and pathogens in samples.
Prevents health hazards and ensures hygiene standards.
Soil Quality
Analyzes fertility, contaminants, and nutrient levels in soil.
Helps in agriculture, landscaping, and environmental studies.
Sludge
Examines sludge for toxins, metals, and organic matter.
Ensures safe disposal, reuse, or treatment compliance.
Noise Level
Measures overall noise exposure in different environments.
Helps reduce noise pollution and maintain safe sound levels.
Lux Level
Tests illumination levels in workplaces, offices, and industries.
Ensures proper lighting for safety, comfort, and productivity.
What Our Customers Say
Testimonials
Shiva Chaudhary
S&R Envirolab provided us with accurate water and air quality reports. Their timely service helped us clear compliance without any hassle.
Akash Kumar Mishra
We rely on S&R Envirolab for regular stack emission and noise monitoring. Their team is professional, detailed, and highly reliable.
Sarita Singh
Thanks to S&R Envirolab, we identified critical issues in indoor air quality and improved workplace safety for our staff.
Mahima Kapoor
The soil and microbiological testing services from S&R Envirolab were extremely thorough. Highly recommended for industries and construction projects.
Request a Quote
Ready to Work Together? Send your needs now !
Learn More From
Frequently Asked Questions
S&R Envirolab LLP is a professional environmental testing and monitoring laboratory committed to delivering reliable, accurate, and timely results. We specialize in a wide range of services including stack emission monitoring, air and noise quality assessments, water analysis, soil and sludge testing, microbiological analysis, and lux level measurement. With state-of-the-art equipment and a team of skilled experts, we ensure every test is conducted in line with national and international standards to meet regulatory compliance and safeguard environmental health.
Our mission is to support industries, institutions, and communities in achieving sustainable practices while protecting people and the planet. By providing clear, actionable insights and comprehensive reports, we help clients reduce environmental risks, improve workplace safety, and operate responsibly. At S&R Envirolab, we strive to be a trusted partner in building a cleaner, healthier, and more sustainable future.